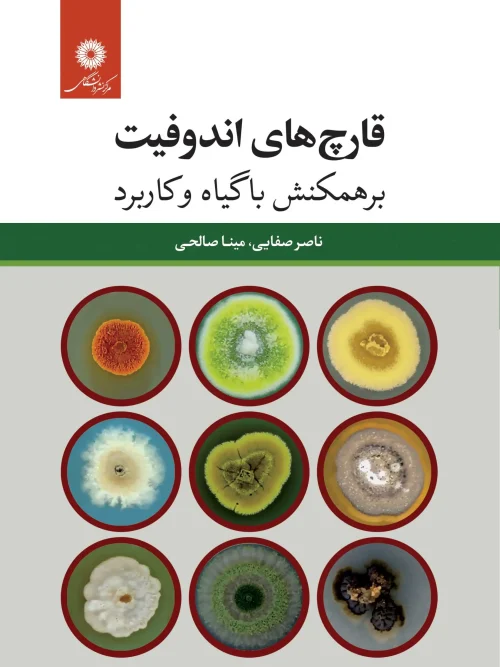

مرکز نشر دانشگاهی
نمایش همه 87 نتیجهمرتبسازی بر اساس محبوبیت
-
10%

کتاب درباره گونه علمی زبان فارسی
قیمت اصلی ۲۰۰,۰۰۰ تومان بود.۱۸۰,۰۰۰ تومانقیمت فعلی ۱۸۰,۰۰۰ تومان است. افزودن به سبد -
10%

کتاب رتبه بندی و پاسخ گویی در آموزش عالی کاربردها و سوء استفاده ها
قیمت اصلی ۲۴۵,۰۰۰ تومان بود.۲۲۰,۵۰۰ تومانقیمت فعلی ۲۲۰,۵۰۰ تومان است. افزودن به سبد -
10%

کتاب لذت ندانستن
قیمت اصلی ۲۵۰,۰۰۰ تومان بود.۲۲۵,۰۰۰ تومانقیمت فعلی ۲۲۵,۰۰۰ تومان است. افزودن به سبد -
10%

کتاب غلط ننویسیم
قیمت اصلی ۲۷۰,۰۰۰ تومان بود.۲۴۳,۰۰۰ تومانقیمت فعلی ۲۴۳,۰۰۰ تومان است. افزودن به سبد -
10%

کتاب سیطره كمیت و علائم آخر زمان
قیمت اصلی ۱۹۵,۰۰۰ تومان بود.۱۷۵,۵۰۰ تومانقیمت فعلی ۱۷۵,۵۰۰ تومان است. افزودن به سبد -
10%

کتاب شرح بی نهایت جلد 2
قیمت اصلی ۸۰۰,۰۰۰ تومان بود.۷۲۰,۰۰۰ تومانقیمت فعلی ۷۲۰,۰۰۰ تومان است. افزودن به سبد -
10%

کتاب انتشار و ارائه آثار علمی
قیمت اصلی ۱۶۰,۰۰۰ تومان بود.۱۴۴,۰۰۰ تومانقیمت فعلی ۱۴۴,۰۰۰ تومان است. افزودن به سبد -
10%

کتاب مبانی گفتمان
قیمت اصلی ۲۷۵,۰۰۰ تومان بود.۲۴۷,۵۰۰ تومانقیمت فعلی ۲۴۷,۵۰۰ تومان است. افزودن به سبد -
10%

کتاب کاربرد هوش مصنوعی در مهندسی نفت
قیمت اصلی ۱۸۵,۰۰۰ تومان بود.۱۶۶,۵۰۰ تومانقیمت فعلی ۱۶۶,۵۰۰ تومان است. افزودن به سبد -
10%

کتاب تکانه زاویه ای در مکانیک کوانتومی
قیمت اصلی ۲۳۰,۰۰۰ تومان بود.۲۰۷,۰۰۰ تومانقیمت فعلی ۲۰۷,۰۰۰ تومان است. افزودن به سبد -
10%

کتاب تربیت معلم مقدماتی زبان
قیمت اصلی ۱۵۵,۰۰۰ تومان بود.۱۳۹,۵۰۰ تومانقیمت فعلی ۱۳۹,۵۰۰ تومان است. افزودن به سبد -
10%

کتاب دینامیک سیالات برای فیزیک دانان
قیمت اصلی ۳۰۰,۰۰۰ تومان بود.۲۷۰,۰۰۰ تومانقیمت فعلی ۲۷۰,۰۰۰ تومان است. افزودن به سبد -
10%

کتاب مدل های مبتنی بر عامل در اقتصاد یک جعبه ابزار
قیمت اصلی ۲۵۰,۰۰۰ تومان بود.۲۲۵,۰۰۰ تومانقیمت فعلی ۲۲۵,۰۰۰ تومان است. افزودن به سبد -
10%

کتاب دولت و محیط زیست
قیمت اصلی ۲۷۰,۰۰۰ تومان بود.۲۴۳,۰۰۰ تومانقیمت فعلی ۲۴۳,۰۰۰ تومان است. افزودن به سبد -
10%

کتاب حساب دیفرانسیل و انتگرال و هندسه تحلیلی
قیمت اصلی ۲۹۵,۰۰۰ تومان بود.۲۶۵,۵۰۰ تومانقیمت فعلی ۲۶۵,۵۰۰ تومان است. افزودن به سبد -
10%

کتاب آمار ریاضی و کاربردهای آن
قیمت اصلی ۴۱۰,۰۰۰ تومان بود.۳۶۹,۰۰۰ تومانقیمت فعلی ۳۶۹,۰۰۰ تومان است. افزودن به سبد -
10%

کتاب علم و دین
قیمت اصلی ۳۳۰,۰۰۰ تومان بود.۲۹۷,۰۰۰ تومانقیمت فعلی ۲۹۷,۰۰۰ تومان است. افزودن به سبد -
10%

کتاب توپولوژی جبری گروه بنیادی
قیمت اصلی ۲۴۵,۰۰۰ تومان بود.۲۲۰,۵۰۰ تومانقیمت فعلی ۲۲۰,۵۰۰ تومان است. افزودن به سبد -
10%

کتاب مسائلی در شیمی آلی جلد اول
قیمت اصلی ۶۷۰,۰۰۰ تومان بود.۶۰۳,۰۰۰ تومانقیمت فعلی ۶۰۳,۰۰۰ تومان است. افزودن به سبد -
10%

کتاب شیمی سبز
قیمت اصلی ۳۸۰,۰۰۰ تومان بود.۳۴۲,۰۰۰ تومانقیمت فعلی ۳۴۲,۰۰۰ تومان است. افزودن به سبد -
10%

کتاب مهارت های ارتباطی برای ارائه دهندگان خدمات سلامت
قیمت اصلی ۲۹۰,۰۰۰ تومان بود.۲۶۱,۰۰۰ تومانقیمت فعلی ۲۶۱,۰۰۰ تومان است. افزودن به سبد -

کتاب رهبری تغییر
۲۸۵,۰۰۰ تومان افزودن به سبد -

کتاب مدیریت دانش و نوآوری در عصر دیجیتال
۲۴۵,۰۰۰ تومان افزودن به سبد -

کتاب فناوری مالی و مالی اسلامی
۱۹۵,۰۰۰ تومان افزودن به سبد -

کتاب تمنای زیبایی
۹۵۰,۰۰۰ تومان افزودن به سبد -

کتاب روش های طراحی کنترل پیش بین مقاوم با رویکرد LMI
۲۹۰,۰۰۰ تومان افزودن به سبد -

کتاب ایمنی شناسی پایه
۲۵۰,۰۰۰ تومان افزودن به سبد -

کتاب اخلاق و مسئولیت پذیری در امور مالی
۱۸۰,۰۰۰ تومان افزودن به سبد -

کتاب روش های آزمایشگاهی پایه در علوم زیستی
۲۶۰,۰۰۰ تومان افزودن به سبد -

کتاب ایجاد مدل کسب و کار بر پایه نوآوری باز
۲۲۵,۰۰۰ تومان افزودن به سبد -

کتاب طبیعت بازارهای گنبدی شهرهای فلات مرکزی ایران
۲۲۰,۰۰۰ تومان افزودن به سبد -

کتاب اقتصاد زیستی
۶۵۰,۰۰۰ تومان افزودن به سبد -
10%
کتاب قارچ های اندوفیت
قیمت اصلی ۳۲۰,۰۰۰ تومان بود.۲۸۸,۰۰۰ تومانقیمت فعلی ۲۸۸,۰۰۰ تومان است. افزودن به سبد -
10%

کتاب نصوص من النثر العربی الحدیث جلد دوم
قیمت اصلی ۱۳۰,۰۰۰ تومان بود.۱۱۷,۰۰۰ تومانقیمت فعلی ۱۱۷,۰۰۰ تومان است. افزودن به سبد -
10%

کتاب آشنایی با معادله بولستمان و فرایندهای انتقال در گازها
قیمت اصلی ۲۸۰,۰۰۰ تومان بود.۲۵۲,۰۰۰ تومانقیمت فعلی ۲۵۲,۰۰۰ تومان است. افزودن به سبد -
10%

کتاب هندسه دیفرانسیل مقدماتی
قیمت اصلی ۳۷۰,۰۰۰ تومان بود.۳۳۳,۰۰۰ تومانقیمت فعلی ۳۳۳,۰۰۰ تومان است. افزودن به سبد -
10%

کتاب مجموعه مقالات مجله معارف درباره ابن سینا
قیمت اصلی ۱۵۰,۰۰۰ تومان بود.۱۳۵,۰۰۰ تومانقیمت فعلی ۱۳۵,۰۰۰ تومان است. افزودن به سبد -
10%

کتاب مبانی تحول
قیمت اصلی ۳۹۰,۰۰۰ تومان بود.۳۵۱,۰۰۰ تومانقیمت فعلی ۳۵۱,۰۰۰ تومان است. افزودن به سبد -
10%

کتاب مواد مهندسی خواص و کاربردهای فلزات و آلیاژها
قیمت اصلی ۳۶۵,۰۰۰ تومان بود.۳۲۸,۵۰۰ تومانقیمت فعلی ۳۲۸,۵۰۰ تومان است. افزودن به سبد -
10%

کتاب شرحی بر رایانش و محاسبات کوانتومی
قیمت اصلی ۲۹۵,۰۰۰ تومان بود.۲۶۵,۵۰۰ تومانقیمت فعلی ۲۶۵,۵۰۰ تومان است. افزودن به سبد -
10%

کتاب دستگاه های مولد پلاسمای غیر حرارتی فشار اتمسفر
قیمت اصلی ۴۱۵,۰۰۰ تومان بود.۳۷۳,۵۰۰ تومانقیمت فعلی ۳۷۳,۵۰۰ تومان است. افزودن به سبد -
10%

کتاب پژوهش نویسی
قیمت اصلی ۳۸۰,۰۰۰ تومان بود.۳۴۲,۰۰۰ تومانقیمت فعلی ۳۴۲,۰۰۰ تومان است. افزودن به سبد -
10%

کتاب چشم اندازهای ارتباطی پاندمی
قیمت اصلی ۱۹۵,۰۰۰ تومان بود.۱۷۵,۵۰۰ تومانقیمت فعلی ۱۷۵,۵۰۰ تومان است. افزودن به سبد -
10%

کتاب شناخت درمانی مبتنی بر بهبود برای اختلالات روانی شدید
قیمت اصلی ۳۸۵,۰۰۰ تومان بود.۳۴۶,۵۰۰ تومانقیمت فعلی ۳۴۶,۵۰۰ تومان است. افزودن به سبد -
10%

کتاب آشنایی با مواد مغناطیسی جلد 2
قیمت اصلی ۳۴۰,۰۰۰ تومان بود.۳۰۶,۰۰۰ تومانقیمت فعلی ۳۰۶,۰۰۰ تومان است. افزودن به سبد -
10%

کتاب هیدرولیک آبیاری سطحی
قیمت اصلی ۱۸۰,۰۰۰ تومان بود.۱۶۲,۰۰۰ تومانقیمت فعلی ۱۶۲,۰۰۰ تومان است. افزودن به سبد -
10%

کتاب شیوه نامه مرکز نشر دانشگاهی
قیمت اصلی ۱۳۲,۰۰۰ تومان بود.۱۱۸,۸۰۰ تومانقیمت فعلی ۱۱۸,۸۰۰ تومان است. افزودن به سبد -
10%

کتاب مقدمه ای بر نانو مواد سنتز خواص و کاربردها
قیمت اصلی ۳۵۰,۰۰۰ تومان بود.۳۱۵,۰۰۰ تومانقیمت فعلی ۳۱۵,۰۰۰ تومان است. افزودن به سبد -
10%

کتاب سلول های خورشیدی مبتنی بر نقاط کوانتومی
قیمت اصلی ۳۳۰,۰۰۰ تومان بود.۲۹۷,۰۰۰ تومانقیمت فعلی ۲۹۷,۰۰۰ تومان است. افزودن به سبد -
10%

کتاب کاربرد فناوری نانو در زیست فناوری حیوانات
قیمت اصلی ۱۸۰,۰۰۰ تومان بود.۱۶۲,۰۰۰ تومانقیمت فعلی ۱۶۲,۰۰۰ تومان است. افزودن به سبد -
10%

کتاب همگرایی علوم و فناوری ها
قیمت اصلی ۴۹۰,۰۰۰ تومان بود.۴۴۱,۰۰۰ تومانقیمت فعلی ۴۴۱,۰۰۰ تومان است. افزودن به سبد -
10%

کتاب جریان های فکری سیاسی و توسعه در جمهوری اسلامی ایران
قیمت اصلی ۱۶۰,۰۰۰ تومان بود.۱۴۴,۰۰۰ تومانقیمت فعلی ۱۴۴,۰۰۰ تومان است. افزودن به سبد -
10%

کتاب آیین نگارش
قیمت اصلی ۱۲۰,۰۰۰ تومان بود.۱۰۸,۰۰۰ تومانقیمت فعلی ۱۰۸,۰۰۰ تومان است. افزودن به سبد -
10%

کتاب ریاضیات انتخاب
قیمت اصلی ۱۴۰,۰۰۰ تومان بود.۱۲۶,۰۰۰ تومانقیمت فعلی ۱۲۶,۰۰۰ تومان است. افزودن به سبد -
10%

کتاب آشنایی با اپتیک
قیمت اصلی ۴۵۰,۰۰۰ تومان بود.۴۰۵,۰۰۰ تومانقیمت فعلی ۴۰۵,۰۰۰ تومان است. افزودن به سبد -
10%

کتاب پادشکنندگی تامین مالی اسلامی
قیمت اصلی ۱۹۵,۰۰۰ تومان بود.۱۷۵,۵۰۰ تومانقیمت فعلی ۱۷۵,۵۰۰ تومان است. افزودن به سبد -
10%

کتاب جنبه انسانی فرایند برنامه ریزی راهبردی در آموزش عالی
قیمت اصلی ۱۲۵,۰۰۰ تومان بود.۱۱۲,۵۰۰ تومانقیمت فعلی ۱۱۲,۵۰۰ تومان است. افزودن به سبد -
10%

کتاب الکترودینامیک پیشرفته
قیمت اصلی ۴۹۵,۰۰۰ تومان بود.۴۴۵,۵۰۰ تومانقیمت فعلی ۴۴۵,۵۰۰ تومان است. افزودن به سبد -
10%

کتاب انشانویسی فارسی در شبه قاره (هند و پاکستان)
قیمت اصلی ۱۰۵,۰۰۰ تومان بود.۹۴,۵۰۰ تومانقیمت فعلی ۹۴,۵۰۰ تومان است. افزودن به سبد -
10%

کتاب نظریه خمیری در ژئومکانیک
قیمت اصلی ۲۵۰,۰۰۰ تومان بود.۲۲۵,۰۰۰ تومانقیمت فعلی ۲۲۵,۰۰۰ تومان است. افزودن به سبد -
10%

کتاب خاک، آب و رشد گیاه
قیمت اصلی ۲۸۵,۰۰۰ تومان بود.۲۵۶,۵۰۰ تومانقیمت فعلی ۲۵۶,۵۰۰ تومان است. افزودن به سبد -
10%

کتاب سیاست غذا
قیمت اصلی ۱۵۰,۰۰۰ تومان بود.۱۳۵,۰۰۰ تومانقیمت فعلی ۱۳۵,۰۰۰ تومان است. افزودن به سبد -
10%

کتاب تحرک آکادمیک
قیمت اصلی ۱۴۰,۰۰۰ تومان بود.۱۲۶,۰۰۰ تومانقیمت فعلی ۱۲۶,۰۰۰ تومان است. افزودن به سبد -
10%

کتاب بازاریابی حسی در ورزش
قیمت اصلی ۱۳۰,۰۰۰ تومان بود.۱۱۷,۰۰۰ تومانقیمت فعلی ۱۱۷,۰۰۰ تومان است. افزودن به سبد -
10%

کتاب وزن و قافیه شعر فارسی
قیمت اصلی ۱۰۰,۰۰۰ تومان بود.۹۰,۰۰۰ تومانقیمت فعلی ۹۰,۰۰۰ تومان است. افزودن به سبد -
10%

کتاب نظریه های مشاوره و روان درمانی
قیمت اصلی ۲۵۰,۰۰۰ تومان بود.۲۲۵,۰۰۰ تومانقیمت فعلی ۲۲۵,۰۰۰ تومان است. افزودن به سبد -
10%

کتاب سیر فلسفه در جهان اسلام
قیمت اصلی ۳۵۰,۰۰۰ تومان بود.۳۱۵,۰۰۰ تومانقیمت فعلی ۳۱۵,۰۰۰ تومان است. افزودن به سبد -
10%

کتاب جزء و کل
قیمت اصلی ۲۱۲,۰۰۰ تومان بود.۱۹۰,۸۰۰ تومانقیمت فعلی ۱۹۰,۸۰۰ تومان است. افزودن به سبد -
10%

کتاب مبانی نظری باستان شناسی
قیمت اصلی ۲۱۰,۰۰۰ تومان بود.۱۸۹,۰۰۰ تومانقیمت فعلی ۱۸۹,۰۰۰ تومان است. افزودن به سبد -
10%

کتاب تمهیدات
قیمت اصلی ۳۰۰,۰۰۰ تومان بود.۲۷۰,۰۰۰ تومانقیمت فعلی ۲۷۰,۰۰۰ تومان است. افزودن به سبد -

کتاب گروه های خطی و کاربردهای آن
اطلاعات بیشتر -

کتاب الرساله الکمالیه فی الحقائق الالهیه
اطلاعات بیشتر -

کتاب هندسه محاسباتی الگوریتم ها و کاربردها جلد 2
اطلاعات بیشتر -

کتاب مقامات حمیدی
اطلاعات بیشتر -

کتاب کارآفرین درون سازمانی
اطلاعات بیشتر -

کتاب استراتژی ساده تر بهتر
اطلاعات بیشتر -

کتاب میکروبیولوژی خرما
اطلاعات بیشتر -

کتاب امنیت اطلاعات امنیت سایبری و حفاظت از حریم خصوصی سیستم مدیریت امنیت اطلاعات الزامات
اطلاعات بیشتر -

کتاب کارآفرینی
اطلاعات بیشتر -

کتاب روانشناسی اجتماعی
اطلاعات بیشتر -

کتاب واژشناسی
اطلاعات بیشتر -

کتاب سفینه تبریز
اطلاعات بیشتر -

کتاب آموزش ترجمه
اطلاعات بیشتر -

کتاب تاریخ فلسفه در اسلام
اطلاعات بیشتر -

کتاب ریشه های اجتماعی دیکتاتوری و دموکراسی
اطلاعات بیشتر -

کتاب مستندسازی
اطلاعات بیشتر -

کتاب تاملات در فلسفه اولی
اطلاعات بیشتر